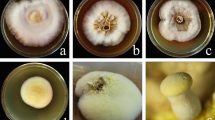

Abstract
Tuber borchii forms ectomycorrhiza with oaks, hazel, and pines, including Pinus sylvestris. However, its ectomycorrhiza morphotype with P. sylvestris was not comprehensively described so far, and molecular analyses are missing despite a high danger of misidentification of T. borchii ectomycorrhiza with other closely related and less valuable truffle species. We described for the first time the morphology and anatomy of T. borchii-P. sylvestris ectomycorrhiza using differential interference contrast technique and semi-thin sections in combination with molecular confirmation of identity. Color of ectomycorrhiza is reddish to dark brown, and morphotypes are unevenly but densely covered by warts-bearing pin-like cystidia. All layers of the hyphal mantle are pseudoparenchymatous with outer mantle layer formed of epidermoid cells. T. borchii ectomycorrhiza was identified by a molecular comparison with fruitbodies used for inoculation and its respective ectomycorrhizae. T. borchii has a wide ecological amplitude. To get a better insight in mycorrhization requirements, we investigated growth of P. sylvestris and its ectomycorrhiza infection rate with T. borchii in substrate with different lime content. The mycorrhization of P. sylvestris with T. borchii in the mycorrhization substrate and cultivation in greenhouse conditions was successful, with colonization of P. sylvestris varying between 36.5 and 48.1%. There was no significant correlation of mycorrhization to applied lime contents, and consequently to pH in substrate, while the increased levels of lime improved growth of the P. sylvestris seedlings.
Similar content being viewed by others
Introduction
The genus Tuber (truffles sensu stricto) is the major genus of ectomycorrhizal fungi within the Tuberaceae (order Pezizales) producing hypogeous ascocarps (Paolocci et al. 2004; Læssøe and Hansen 2007). Following phylogenetic species criteria, the worldwide number of Tuber species is reported to be more than 200 (Bonito et al. 2010, Wei et al. 2021), of which at least 30 species occur in Europe (Stobbe et al. 2013; Molinier et al. 2016). All species of this genus are ectomycorrhizal (Agerer 1987–2012). Due to their below-ground life cycle, special features have evolved in the ascocarps, including an intense release of odor to attract spore vectors (Frank et al. 2006; Strojnik et al. 2020). Therefore, some truffles are of great economic value including T. borchii Vittad. (bianchetto, whitish truffle) that shares a garlic-like odor, excellent gastronomic properties, and unique aromas with Tuber magnatum Picco (Italian white truffle) (Zambonelli et al. 2021), as well as Tuber melanosporum Vittad. (Périgord black truffle), and Tuber aestivum Vittad. (Summer black truffle) (Hall et al. 2007; Belfiori et al. 2016). Although T. borchii is an excellent truffle, it has been undervalued in trading and culinary (Hall et al. 2007). Among truffles cultivated in orchards, T. melanosporum dominates with more than half of all traded truffles worldwide and with up to 80% of all French truffle production (Hall et al. 2003; Mello et al. 2006). While T. melanosporum and T. aestivum plantations were established worldwide wherever suitable conditions exist (Bajaj et al. 2021), T. borchii can be cultivated in areas where other economically important truffle species grow with less or little success (Zambonelli et al. 2002). Up to our knowledge, it is being successfully cultivated at least in New Zealand, Australia, and the USA (Zambonelli et al. 2015) due to its low host specificity and its growth in a wide range of soils (Iotti et al. 2010). In Germany, there are no known T. borchii plantations, and only a few were established in Europe (Belfiori et al. 2016) most likely due to commercial and cultivation dominance of T. melanosporum and T. aestivum.
Tuber borchii is native throughout Europe, from the Mediterranean south to as far north as central Finland, and from Ireland to Hungary in Europe (GBIF 2021). Recent records indicate presence of this species also in Iran, Middle East (Puliga et al. 2021). The species was introduced through cultivation in several countries overseas (Benucci et al. 2012; Zambonelli et al. 2015). T. borchii is fruiting in soils with variable carbonate content and broad pH ranging from slightly acidic (5.2) 6.5 to as basic as 7.8 (Gardin 2005; Mello et al. 2006; Hall et al. 2007). Due to its broad ecological amplitude, it can be cultivated on marginal lands (Benucci et al. 2012) with a range of plant ectomycorrhizal partners such as oaks, pines, hazel, and chestnut (Hall et al. 2007; Iotti et al. 2010). It was also successfully inoculated on Tilia platyphyllos (Giomaro et al. 2000) and Carya illinoinensis (Benucci et al. 2012), the latter one indicating possibility to grow nuts and truffles simultaneously in organic farming (Benucci et al. 2012; Freiberg et al. 2021). However, T. borchii prefers gymnosperm hosts (Bonito et al. 2010). Among gymnosperms, Mediterranean Pinus species such as P. pinaster and P. pinea are known hosts of T. borchii (Iotti et al. 2010) as well as synthesis of the mycorrhiza of T. borchii with P. radiata was described in pure culture (Duñabeitia et al. 1996). Prior to these studies, several successful mycorrhizations of T. borchii (as Tuber albidum Pico.) with Pinus strobus were realized in Italy in 1960ies and 1970es (Palenzona and Fontana 1970).
Pinus sylvestris is a robust tree species. Naturally, it grows on nutrient-poor, sandy soil, rocky outcrops, peat bogs, or close to the forest limit (Mátyás et al. 2004). P. sylvestris was also mentioned to form ectomycorrhiza with T. borchii (Hall et al. 2007), and the combination of these two species, both with broad ecological amplitude, makes an ideal combination for the afforestation of marginal or devastated yet not contaminated lands such as post-excavation brown coal area in Lusatia (southern Brandenburg, Germany). This approach can successfully improve socio-economic wellbeing of the people living in this area. In Germany, both species are native, P. sylvestris widely present (Mátyás et al. 2004), while for T. borchii, a personal communication with truffle collectors indicated its scattered distributed in areas Leinebergland (Lower Saxsony), Kallmuth (North Rhine Westfalia), Kaiserslautern (Rhineland Palatinate), Papproth (Brandenburg), and Gramschatzer Wald (Bavaria).
Ectomycorrhiza of T. borchii was morphologically and anatomically described to a different extent from several plant partners such as Quercus spp. (Zambonelli et al. 1993), Pinus pinea (Zambonelli 1995), Pinus radiata (Duñabeitia et al. 1996), Pinus strobus (Palenzona and Fontana 1970), Corylus avellana (Rauscher et al. 1996), Tilia platyphyllos (Giomaro et al. 2000), and Carya illinoinensis (Benucci et al. 2012). As far as we know, no comprehensive description of T. borchii ectomycorrhiza was published with P. sylvestris. Common features of all T. borchii ectomycorrhizas from different plant hosts are a needle-shaped long cystidia, and a puzzle-like hyphal mantle (Rauscher et al. 1996; Benucci et al. 2012). The shape of the mantle cells can vary depending on the host plant and fungal strain, ranging from polygonal to epidermoid shapes, making this ectomycorrhiza difficult to distinguish anatomically from other small white truffles or from mixed ectomycorrhiza samples (Giomaro et al. 2000). Specific primers have been developed to identify morphologically similar truffle species (Mello et al. 2006) but sequencing of the complete ITS region in nuclear ribosomal DNA is currently most reliable molecular tool to identify T. borchii, and to separate it from other morphologically similar small white truffles and their ectomycorrhizas (Benucci et al. 2012).
The aim of our paper was to test mycorrhizal colonization of T. borchii on P. sylvestris at different lime contents in an inoculation substrate, and to comprehensively characterize its ectomycorrhiza. In addition, we confirmed the identity of ectomycorrhiza and sporocarps, used for inoculation, by sequencing of the ITS region of in the rDNA. As far as we know, no experimental study is available investigating the effect of different lime contents on mycorrhizal parameters and growth of P. sylvestris seedlings in greenhouse conditions. We expected to gain information on the ecological amplitude of T. borchii ectomycorrhiza and the influence of pH on the mycorrhizal colonization rate.
Material and methods
Growth parameters and mycorrhizal colonization rate
Seedlings of P. sylvestris inoculated with T. borchii were prepared and cultivated at the German truffle nursery Trüffelbaumschule in Freiburg, Baden-Württemberg (47.997 N, 7.843 E) (www.trueffelbaumschule.de, Silke Friedrich). A spore suspension was prepared from 20 T. borchii ascocarps collected in region Abruzzo (Italy) and obtained from a commercial truffle dealer. Truffles were thoroughly washed, cleaned of damaged or rotten parts, frozen till preparation of spore suspension, and grinded in water prior to mycorrhization. An adequate volume of spore suspension containing 1.3 g (fresh weight) of truffles was used for mycorrhization of individual seedling. Seedlings were grown in 500 mL pots filled with a standard substrate that is regarded as trade secret of the nursery. The standard substrate was supplemented with 0 g, 5 g, 10 g, or 15 g of limestone per pot (T0, T5, T10, or T15, respectively) in form of a mixture of various CaCO3 particle sizes (Table 1): limestone gravel (2–8 mm), finely grounded (1–2 mm) limestone sand, and limestone dust (MilliporeSigma Cat. No. 310034). Limestone supplement was mixed in substrate well prior to beginning of the experiment to ensure adequate and uniform distribution of lime particles in pots and stabilization of pH. Germinated seeds and a spore suspension of Tuber borchii were added to the pots. Seedlings were kept at the truffle nursery for 9 months at a temperature of 15 °C in autumn and spring and at 25 °C in summer.
At the end of experiment, pots with inoculated seedlings were transferred to the Centre for Agricultural Landscape Research in Müncheberg, Märkisch-Oderland (Germany) for immediate disassembly and measurements. For all seedlings, shoot height (from a root collar to a tip bud) was measured; shoot was removed from the roots and dried to a constant weight (air dryer, 60 °C; WTB Binder B28, Binder GmbH, Tuttlingen, Germany). Roots were gently removed from the substrate and washed under the tap water to remove the adhering substrate. Free remaining substrate from each pot was individually measured for pH (in water; pH meter HI 2223 Calibration Check pH/ORP Meter, Hanna Instruments Ltd., Leighton Buzzard, UK). All ectomycorrhiza root tips were morphologically screeded and identified following Agerer (1987–2012). All root tips and ectomycorrhiza of T. borchii (other mycorrhizae were not observed) were counted under a binocular microscope to calculate the mycorrhizal colonization rate. Tips of T. borchii with fully developed morphological characteristics were harvested for morphology and anatomy of ectomycorrhizae and for the molecular analyses. Afterwards, roots were dried using same procedure as above. Dried shoots and roots were weighted and root to shoot ratio calculated.
Morphology and anatomy of ectomycorrhizae
Morphological and anatomical descriptions of T. borchii ectomycorrhizae were performed according to Rauscher et al. (1996). Descriptions are based on 20 mature ectomycorrhiza, kept fixed as described below. Anatomical preparations were investigated and measured in water. Photographs were taken with Zeiss, AxioImager Z2 microscope (Carl Zeiss Microscopy GmbH, Jena, Germany) using differential interference contrast technique.
For preparation of semi-thin sections, mycorrhizal tips were fixed in 2% glutaraldehyde in 0.1 M sodium cacodylate buffer (pH 7. 2) and kept refrigerated at +4 °C until further processing. Following six transfers in 0.1 M sodium cacodylate buffer, samples were postfixed in 1% osmium tetroxide and kept in the same buffer for 2 h in the dark at room temperature. After five washes in distilled water, samples were dehydrated in acetone line, namely, in 30%, 50%, and 70% each for 15 min, followed by 80%, 90%, and 99.9% each for 30 min, and finally, in 100% acetone, three times for 1 h. After dehydration, the samples were embedded in Spurr’s resin (Spurr 1969). Twenty mycorrhizae were cut with a diamond knife on an Ultracut Reichert ultramicrotome (W. Reichert-LABTEC, Wolfratshausen, Germany). The Sects. (0.6–0.7 µm) were stained with crystal violet for light microscopy (Zeiss Axioskop 50, Oberkochen, Germany).
DNA extraction, amplification, and sequencing
DNA was extracted from dried truffles collected nearby Papproth (Brandenburg, Germany), from truffles used for inoculation, and from ectomycorrhizal root tips using a DNeasy Plant Mini Kit (Qiagen, Hilden, Germany). The complete nrDNA internal transcribed spacer (ITS) sequence was amplified with the primer pair ITS1/ITS4 (White et al. 1990). PCR conditions were set according to the protocol of Melanda et al. (2020). Amplification reactions were performed in a PE 9700 DNA thermocycler (Applied Biosystems, Foster City, CA, USA), with an annealing temperature of 55 °C. Before sequencing, amplified products were separated in 1.5 × agarose gel, cut from the gel, and cleaned using the Wizard SV Genomic DNA Purification System Kit (Promega Corporation, Madison, WI, USA). DNA was sequenced at Macrogen (Macrogen Europe B.V., Amsterdam, The Netherlands) with the same primers as used in PCR. Sequencher 5.4.6 (Gene Codes Corporations, Ann Arbor, MI, USA) was used to assemble consensus sequences from the two DNA strands of each isolate. The sequences obtained from the isolates were identified to the highest similarity using an online BLASTN algorithm and comparing them with those available in the GenBank database (Altschul et al. 1997).
Statistics
Data were evaluated in Statistica (data analysis software system), version 13, TIBCO Software Inc. (2018) http://tibco.com. Growth parameters were subjected to a one-way ANOVA with a substrate treatment as a categorical factor. Equality of variances was tested by Levene test at P < 0.05. Where ANOVA showed statistically significant effect of substrate treatment, significant differences among groups were identified by post hoc Tukey’s HSD test. Where equality of variances was not met and could not be achieved by transformation of data, non-parametric Kruskal–Wallis test was performed. Data were considered as significantly different at P < 0.05.
Results
Pine growth parameters and mycorrhizal colonization rate
Five seedlings were measured for each substrate variant. An increased amount of lime in inoculation substrate resulted in a statistically significant increase of shoot height (F = 3.46, P = 0.0416), while other measured parameters (i.e., shoot dry weight, root dry weight, root to shoot ratio, number of root tips) were not significantly affected (Table 2). Shoots were significantly higher (P = 0.0304) in the T15 substrate (Table 2). Although not statistically significant, mean shoot and root dry weights were correspondingly the lowest in the T0 and the highest in the T15 substrate. pH values at the end of the experiment varied from 6.94 to 7.49 in limed pots (Table 2). All ectomycorrhizal fine roots were morphologically identified as T. borchii, and no other types of ectomycorrhiza were observed on tested seedlings. Individual seedlings showed highly variable mycorrhizal colonization rates ranging from 8.0 to 84.9% (both observed in treatment T5), while mean values were between 36.5 ± 2.75% in T10 and 48.1 ± 7.40% in T15. Evidently, the most variable colonization rates were encountered in T5 treatment. However, a typical and well-developed ectomycorrhizas with cystidia were only present in the treatments T0 and T5. In the T10 and T15 ectomycorrhizal root tips with few or no cystidia were formed.
Morphology and anatomy of ectomycorrhizae
Ectomycorrhizal systems were dichotomously ramified or unramified. Mycorrhizae were reddish to dark brown (7.5YR 5/8 to 5YR 6/12; Munsell 1954), with growing tip of a lighter color (7.5YR 9/8 to 7.5YR 9/6; Munsell 1954). The whole ectomycorrhiza root tips from lower lime concentrations were covered by cystidia which were denser towards the root tip (Fig. 1), while scarce or no cystidia were observed in ectomycorrhiza from > 10 g lime/500 ml mycorrhization substrate (data not shown). Ectomycorrhizal hyphal mantle was composed of 3–7 (9) cell layers (Fig. 2a, b). Outer cells of the root cortex look dead and are filled with tannins, a common characteristic for pine ectomycorrhizas. In root tips where the very tip was still growing, the Hartig net was only developed in the basal parts of the ectomycorrhiza (Fig. 2a). The presence of nuclei in cortex cells proved that cells were active (Fig. 2b). Emanating hyphae, rhizomorphs, sclerotia, laticifers or excreting latex, mantle dots, or carbonizing of ectomycorrhizae were not observed.
a Semi-thin longitudinal section of the dichotomously branched Tuber borchii-Pinus sylvestris ectomycorrhiza. Hyphal mantle (hm) surrounds the tip and Hartig net (Hn) grows in the basal parts of the mycorrhiza. Meristem (M) is active. CC, cortical cells; S, stele. Bar = 100 µm. b Magnification of the longitudinal section of the Tuber borchii-Pinus sylvestris ectomycorrhiza. N, nucleus; Hn, Hartig net; hm, hyphal mantle; C, cystidium. Bar = 40 µm
Anatomical characters of mantle in a plan view
Mantle complete, all mantle layers are pale yellowish-brown with membranaceous position of pigment within the cell wall, cell content absent. All mantle layers are pseudoparenchymatous (Fig. 3). Cells of outer mantle layer are epidermoid to irregularly angular, bearing a hyphal net. Hyphae of hyphal net often form bundles. Cells of hyphal net 5–34 μm × 2–14 μm, hyphal cell walls distinct, 0.2–1.6 μm. Clamps are absent. Cells of outer mantle layer not specifically arranged. Cells of outer mantle layer elongated to almost roundish (3–31 μm × 2–21 μm). Cell walls 0.2–4.6 μm, smooth. Middle mantle layer pseudoparenchymatous, cells arranged without pattern, the same shape as outer mantle (3–24 μm × 2–13 μm), cell walls 0.2–2.2 μm, smooth. Inner mantle layer pseudoparenchymatous, cells arranged without pattern, same shape as outer mantle (3–39 μm × 2–13 μm), cell walls 0.2–1.5 μm, smooth. Cells of the outer mantle organized in a similar manner as other parts (1.5–20.0 μm × 1–13 μm), cell walls 0.3–2.3 μm, smooth. Hartig net with lobes 1.05–4.77 (mean 2.16 ± 0.04 μm).
Anatomy of the emanating elements
Emanating hyphae were not observed. Cystidia originating from the hyphal net covering the outer mantle or the outer mantle itself, awl-shaped (type A), non-ramified, with 0, 1, or 2 septa at the basal part of cystidium, septa simple, foot cell absent. Length of cystidia ranging from 33 to 168 μm (mean ± std.err.: 87.4 ± 2.77 μm) (Fig. 4). Proximal diameter 2.7–8.2 μm (4.84 ± 0.07 μm), medial diameter 1.5–3.7 μm (2.51 ± 0.04 μm), distal/apical diameter 0.6–3.5 (4.6) μm (1.74 ± 0.04 μm). Cell walls 0.4–2.5 μm (0.90 ± 0.02 μm) at the base, 0.4–1.2 μm (0.82 ± 0.02 μm) in the middle, and 0.2–1.2 μm (0.42 ± 0.01 μm) at the apex. Cell walls of cystidia often covered by warts (Supplementary Fig. S1), particularly at the apex.
Molecular analyses of fruitbodies and ectomycorrhizae
Three mature truffles collected nearby Papproth (Brandenburg, Germany), all collected within the radius of < 20 m, were sequenced, and resulted in three identical sequences (OM002609-11). Obtained sequences were 100% identical with T. borchii from oak dominated lowland forest in Slovenia (FM205502) and with a range of sequences published in phylogenetic or diversity studies including T. borchii ascocarps (Bonuso et al. 2010; Marjanović et al. 2010). Sequencing of three randomly selected ectomycorrhiza from inoculated P. sylvestris seedling confirmed the identity with T. borchii (OM0026012-14).
Discussion
Truffle inoculation substrates are in general a producer’s secret, and only rarely information on exact composition or substrate optimisation is given (Weden et al. 2004, Freiberg et al 2021). Similarly, optimal conditions for plantation soil adaptation are broad and not necessarily adapted to a specific truffle and tree species. P. sylvestris inoculated with T. borchii was rarely used in a large-scale plantation and truffle cultivation activities. Garcia-Montero et al. (2007) even concluded that combination of Pinus nigra and P. sylvestris mycorrhized with T. melanosporum is unfavorable, yet some fine-tuning of conditions can yield success, as is a case in combination of joined pecan and truffle cultivation (Freiberg et al. 2021). As different truffle species have different ecological requirements (Hall et al. 2003), any information regarding adaptation of substrate composition, nutrients content, or optimal plantation soil conditions is a relevant for science and in a plantation content. T. borchii inoculation of P. sylvestris seedlings was successful regardless to the lime content used in the mycorrhization substrate and cultivation in greenhouse conditions. Mycorrhization levels did not differ significantly among different amounts of added lime while highest mycorrhization percentage average was observed for highest lime content indicating species’ high ecological plasticity in terms of lime requirements. All limestone weight variants resulted in mycorrhization level and quality, sufficient for a positive commercialization certification of seedlings (Donnini et al. 2014). pH values at the end of the experiment increased but remained in the truffle physiology range across treatments amplitude (Gardin 2005; Hall et al. 2007). Observed pH plasticity indicates that optimization of substrate with lime in case of T. borchii, unlike for some other host-mycorrhizal fungi, is not necessary (Freiberg et al. 2021). High mycorrhization levels, relative low effect of pH, and difference in lime content in inoculation substrate also indicate an easy greenhouse mycorrhization with T. borchii (Donnini et al. 2009) and confirms its broad ecological amplitude (Gardin 2005; Hall et al. 2007). However, observations from greenhouse remain to be confirmed in plantations through a successful truffle fructification. In addition, a modified plantation would be required as current management applied for truffle cultivation, such as tree pruning, could be not compatible with tree growth requirement for wood purpose. High species plasticity can explain its wide geographic distribution and occurrence in non-typical truffles sites such as devastated lands such as post-excavation brown coal area in Lusatian or high altitudinal frost areas with podzol soils (Grebenc et al. 2010).
Although T. borchii colonization did not significantly differ between lime treatments, the plant partner showed trends in improved growth in higher lime content in the mycorrhization substrate and cultivation in greenhouse conditions. Shoots of P. sylvestris seedlings were significantly higher in treatment with the highest lime addition compared to treatment with no lime addition. This can be due to quicker percolation, better retention of irrigation water through the substrate, and higher minerals weathering from gravel and lime dust content (van Schöll et al. 2006; Leake et al. 2008) in combination with an increased nitrate–N and extractable P following liming which all lead to improved productivity of the substrate (Mkhonza et al. 2020). Our findings support the idea that seedlings and mycorrhizae of T. borchii on P. sylvestris can thrive in various conditions that are often met in native habitats of P. sylvestris but may improve the tree growth only in conditions with higher limestone content.
Mycorrhizae of T. borchii are relatively well morpho-anatomically characterized from several hosts. However, different levels of accuracy in descriptions are to note, making comparison challenging. Emanating hyphae that were reported by Zambonelli et al. (1993, 1995), Rauscher (1996), and Duñabeitia et al. (1996) were not observed in our case, as they were not reported by Giomaro et al. (2000) and Benucci et al. (2012). However, hyphal net that was observed by Rauscher et al. (1996) and Duñabeitia et al. (1996) was evident. Hyphae of hyphal net in our case often occurred in bundles which is not evident from descriptions and graphics of Rauscher et al. (1996) and Duñabeitia et al. (1996). Mean length, proximal, and apical diameters of cystidia were in the range reported for T. borchii on P. pinaster (Zambonelli et al. 1995), but with greater span of values in our case. Similar lengths of cystidia for T. borchii were reported for Corylus avellana, Quercus (DEEMY-An Information System for Characterization and DEtermination of EctoMYcorrhizae, Agerer and Rambold 2004–2005), Tilia platyphyllos (Giomaro et al. 2000) and Carya illinoinensis (Benucci et al. 2012). On the other hand, for T. borchii on P. radiata minimum length of cystidia that is almost six times greater compared to our minimum values and maximum length that is 1.5-times of our maximum length was reported (Duñabeitia 1996). It is to note that inoculated P. radiata seedlings were grown in pure culture on Melin-Norkrans medium, whereas our report is from an inoculation substrate grown ectomycorrhizae. In our case, well-formed mycorrhiza with cystidia were only found in the T0 and T5 substrate treatments. This may be due to better irrigation of the substrates, since limestone gravel and finely grounded limestone are quantitatively higher in the T10 and T15 treatments. Thus, the flow rate and distribution of water could be better in these treatments. On the other hand, the absence of the cystidia could be an ontogenetical stage. Very young cultures of P. sylvestris-T. borchii ectomycorrhiza from the greenhouse showed a lack of cystidia on their mycorrhizae while older cultures bore plenty T. borchii mycorrhizae with well-developed cystidia. Therefore, we believe that the lack of cystidia is due to the ontogenetical stage of the mycorrhizae.
Surface of cystidia was covered by warts, so far only reported for Corylus (Rauscher et al. 1996). Warts were also described for Tuber magnatum, another among the white truffles (Mello et al. 2001). Cystidia contained 0–2 septa, and the same number of septa was also reported by Giomaro et al. (2000). However, one of the strains investigated by Giomaro et al. (2000) contained three septa.
Mean length of cells in outer mantle layer was slightly lower compared to the reports of Giomaro et al. (2000) and Benucci et al. (2012). Compared to the description of Rauscher et al. (1996) who noted mantle cell walls thickness of 1.0 µm in outer layer, and up to 0.5 µm in inner layer, our samples revealed greater span of cell wall thickness in all mantle layers, i.e., 0.2–4.6 μm in outer, 0.2–2.2 μm in middle, and 0.3–2.3 μm in inner mantle layer. As evident, even in the middle and inner mantle layer, some cell walls were relatively thick.
As reported for different strains of T. borchii, cell shape of outer mantle may vary from polygonal with rounded edges to epidermoid with marked lobes (Giomaro et al. 2000). Variable cell shape was also reported for T. borchii from Carya illinoinensis, from ellipsoid and isodiametric to irregular-rectangular and elongated (Benucci et al. 2012). Shapes of cells were variable also in our case, but with prevailing epidermoid type. Giomaro et al. (2000) pointed out that solely the outer mantle organization cannot be used to distinguish among ectomycorrhizae from different species in the “white truffles.”
Conclusions
The mycorrhization of P. sylvestris with T. borchii in the mycorrhization substrate and cultivation in greenhouse conditions was successful. Lime and consequently pH did not affect mycorrhization levels, but it improved growth of the P. sylvestris seedlings. With our study, it was shown that T. borchii can form ectomycorrhizae with P. sylvestris in substrates with different amounts of limestone, therefore, making it a potential candidate for a wide variety of substrates. Although the colonization rates were insignificantly different among treatments, the carbonate content might be decisive in future developmental steps including sporocarp production of other truffle species as is a case in T. melanosporum (Garcia-Montero et al. 2012). Opposite to mycorrhization, we have shown that improved growth of P. sylvestris seedlings occurred only in substrate with higher limestone contents. Morpho-anatomical properties of T. borchii on P. sylvestris are similar as described for T. borchii on other tree species, with the exception that hyphae of hyphal net occurred in bundles.
Data availability
The raw data is deposited in the public nucleotide database or is available at the first author.
References
Agerer R, Rambold G (2004–2005) DEEMY – an information system for characterization and determination of ectomycorrhizae. München, Germany. http://www.deemy.de. Accessed 21 Oct 2015
Agerer R (1987–2012) Colour atlas of ectomycorrhizae. Einhorn, Schwäbisch-Gmünd
Altschul SF, Madden TL, Schaffer AA, Zhang J, Zhang Z, Miller W, Lipman DJ (1997) Gapped BLAST and PSI-BLAST: a new generation of protein database search programs. Nucleic Acids Res 25(17):3389–3402. https://doi.org/10.1093/nar/25.17.3389
Bajaj SR, Marathe SJ, Grebenc T, Zambonelli A, Shamekh S (2021) First report of European truffle ectomycorrhiza in the semi-arid climate of Saudi Arabia. 3 Biotech 11(1):1–9. https://doi.org/10.1007/s13205-020-02559-w
Belfiori B, Riccioni C, Paolocci F, Rubini A (2016) Characterization of the reproductive mode and life cycle of the whitish truffle T. borchii. Mycorrhiza 26:515–527. https://doi.org/10.1007/s00572-016-0689-0
Benucci GMN, Bonito G, Falini LB, Bencivenga M (2012) Mycorrhization of Pecan trees (Carya illinoinensis) with commercial truffle species: Tuber aestivum Vittad. and Tuber borchii Vittad. Mycorrhiza 22:383–392. https://doi.org/10.1007/s00572-011-0413-z
Bonito GM, Gryganskyi AP, Trappe JM, Vilgalys R (2010) A global meta-analysis of Tuber ITS rDNA sequences: species diversity, host associations, and long-distance dispersal. Mol Ecol 19:4994–5008. https://doi.org/10.1111/j.1365-294X.2010.04855.x
Bonuso E, Zambonelli A, Bergemann SE, Iotti M, Garbelotto M (2010) Multilocus phylogenetic and coalescent analyses identify two cryptic species in the Italian bianchetto truffle. Tuber Borchii Vittad Conserv Gen 11(4):1453–1466. https://doi.org/10.1007/s10592-009-9972-3
Donnini D, Benucci GM, Bencivenga M, Falini LB (2014) Quality assessment of truffle-inoculated seedlings in Italy: proposing revised parameters for certification. Forest Systems 23(2):385–393. https://doi.org/10.5424/fs/2014232-05029
Donnini D, Falini L, Massimo G, Benucci GMN, Bencivenga M (2009) Mycorrhization: Tuber borchii Vittad. competitivity with respect to other species of Tuber. Acta Bot Yunnan 16:100–102
Duñabeitia MK, Hormilla S, Salcedo I, Peña JI (1996) Ectomycorrhizae synthesized between Pinus radiata and eight fungi associated with Pinus spp. Mycologia 88:897–908. https://doi.org/10.2307/3761052
Frank JL, Barry S, Southworth D (2006) Mammal mycophagy and dispersal of mycorrhizal inoculum in Oregon White oak woodlands. Northwest Sci 80:264–273
Freiberg JA, Sulzbacher MA, Grebenc T, Santana NA, Schardong IS, Marozzi G, Fronza D, Giachini AJ, Donnini D, Jacques RJS, Antoniolli ZI (2021) Mycorrhization of pecans with European truffles (Tuber spp., Tuberaceae) under southern subtropical conditions. Appl Soil Ecol 168:104108. https://doi.org/10.1016/j.apsoil.2021.104108
García-Montero LG, Manjón JL, Martín-Fernández S, Di Massimo G (2007) Problems of using pines in Tuber melanosporum culture: soils and truffle harvest associated with Pinus nigra and P. sylvestris. Agrofor Syst 70(3):243–249. https://doi.org/10.1007/s10457-007-9052-y
García-Montero LG, Valverde-Asenjo L, Moreno D, Díaz P, Hernando I, Menta C, Tarasconi K, Zambonelli A, Bonito GM (2012) Edible ectomycorrhizal mushrooms current knowledge and future prospects influence of edaphic factors on edible ectomycorrhizal mushrooms: new hypotheses on soil nutrition and C sinks associated to ectomycorrhizae and soil fauna using the tuber brûlé model. Springer Berlin Heidelberg, Berlin Heidelberg, pp 83–104
Gardin L (2005) I tartufi minori in Toscana. Gli ambienti di crescita dei tartufi marzuolo e scorzone. ARISA Regione Toscana Italy. https://doi.org/10.13140/RG.2.1.2509.5844
GBIF (2021) Tuber borchii Vittad. in GBIF Secretariat (2021) GBIF backbone taxonomy. Checklist dataset https://doi.org/10.15468/39omei. Last accessed via GBIF.org on 2021–11–16
Giomaro G, Zambonelli A, Cecchini D, Stocchi V, Saffi V (2000) Anatomical and morphological characterization of mycorrhizas of five strains of Tuber borchii Vittad. Mycorrhiza 10:107–114. https://doi.org/10.1007/s005720000065
Grebenc T, Bajc M, Kraigher H (2010) Post-glacial migrations of mycorrhizal plants and ectomycorrhizal partners: an example of the genus Tuber. Les (Ljubljana) 62(5):149–154. http://www.dlib.si/?URN=URN:NBN:SI:doc-QMZP67P6
Hall IR, Yun W, Amicucci A (2003) Cultivation of edible ectomycorrhizal mushrooms. Trends Biotechnol 21:433–438. https://doi.org/10.1016/S0167-7799(03)00204-X
Hall IR, Brown GT, Zambonelli A (2007) Taming the truffle: the history, lore, and science of the ultimate mushroom. Timber Press, Portland. https://doi.org/10.13140/2.1.2538.0487
Iotti M, Lancellotti E, Hall I, Zambonelli A (2010) The ectomycorrhizal community in natural Tuber borchii grounds. FEMS Microbiol Ecol 72:250–260. https://doi.org/10.1111/j.1574-6941.2010.00844.x
Læssøe T, Hansen K (2007) Truffle trouble: what happened to the Tuberales? Mycol Res 111:1075–1099. https://doi.org/10.1016/j.mycres.2007.08.004
Leake JR, Duran AL, Hardy KE, Johnson I, Beerling DJ, Banwart SA, Smith MM (2008) Biological weathering in soil: the role of symbiotic root-associated fungi biosensing minerals and directing photosynthate-energy into grain-scale mineral weathering. Mineral Mag 72:85–89. https://doi.org/10.1180/minmag.2008.072.1.85
Marjanović Ž, Grebenc T, Marković M, Glišić A, Milenković M (2010) Ecological specificities and molecular diversity of truffles (genus Tuber) originating from mid-west of the Balkan Peninsula. Sydowia 62(1):273–291
Mátyás C, Ackzelland L, Samuel CJA (2004) EUFORGEN technical guidelines for genetic conservation and use for Scots pine (Pinus sylvestris). International Plant Genetic Resources Institute, Rome, Italy 6. https://doi.org/10.13140/RG.2.2.10976.07682
Melanda GC, Accioly T, Ferreira RJ, Rodrigues AC, Cabral TS, Coelho G, Sulzbacher MA, Cortez VG, Grebenc T, Martín MP, Baseia IG (2020) Diversity trapped in cages: Revision of Blumenavia Möller (Clathraceae, Basidiomycota) reveals three hidden species. PLoS ONE 15(5):e0232467. https://doi.org/10.1371/journal.pone.0232467
Mello A, Fontana A, Meotto F, Comandini O, Bonfante P (2001) Molecular and morphological characterization of Tuber magnatum mycorrhizas in a long-term survey. Microbiol Res 155:279–284. https://doi.org/10.1016/S0944-5013(01)80005-7
Mello A, Murat C, Bonfante P (2006) Truffles: much more than a prized and local fungal delicacy. FEMS Microbiol Lett 260:1–8. https://doi.org/10.1111/j.1574-6968.2006.00252.x
Mkhonza NP, Buthelezi-Dube NN, Muchaonyerwa P (2020) Effects of lime application on nitrogen and phosphorus availability in humic soils. Sci Rep 10(1):8634. https://doi.org/10.1038/s41598-020-65501
Molinier V, Murat C, Baltensweiler A, Büntgen U, Martin F, Meier B, Moser B, Sproll L, Stobbe U, Tegel W, Egli S (2016) Fine-scale genetic structure of natural Tuber aestivum sites in southern Germany. Mycorrhiza 26:895–907. https://doi.org/10.1007/s00572-016-0719-y
Munsell Color (Firm) (1954) Munsell soil color charts. Munsell Color Company
Palenzona M, Fontana A (1970) The influence of type of soil on three forms of pine mycorrhiza. Allionia 16:101–113
Paolocci F, Rubini A, Riccioni C, Arcioni S (2004) Tuber aestivum and Tuber uncinatum: two morphotypes of two species? FEMS Microbiol Lett 235:109–115. https://doi.org/10.1111/j.1574-6968.2004.tb09574.x
Puliga F, Illice M, Iotti M, Leonardi P, Baghdadi A, Mozafari AA, Zambonelli A (2021) True truffle diversity in Iran. Ital J Mycol 50:52–62. https://doi.org/10.6092/issn.2531-7342/12822
Rauscher T, Müller WR, Agerer R, Chevalier G (1996) Tuber borchii Vitt. + Corylus avellana L. Descr Ectomyc 1:173–178
Spurr AR (1969) A low viscosity epoxy resin embedding medium for electron microscopy. J Ultrastruct Res 26:31–43. https://doi.org/10.1016/S0022-5320(69)90033-1
Stobbe U, Egli S, Tegel W, Peter M, Sproll L, Büntgen U (2013) Potential and limitations of Burgundy truffle cultivation. Appl Microbiol Biotechnol 97:5215–5224. https://doi.org/10.1007/s00253-013-4956-0
Strojnik L, Grebenc T, Ogrinc N (2020) Species and geographic variability in truffle aromas. Food Chem Toxicol 142:111434. https://doi.org/10.1016/j.fct.2020.111434
Van Schöll L, Smits MM, Hoffland E (2006) Ectomycorrhizal weathering of the soil minerals muscovite and hornblende. New Phytol 171:805–814. https://doi.org/10.1111/j.1469-8137.2006.01790.x
Wedén C, Chevalier G, Danell E (2004) Tuber aestivum (syn. T. uncinatum) biotopes and their history on Gotland Sweden. Mycol Res 108(3):304–310 https://doi.org/10.1017/S0953756204009256
White TJ, Bruns TD, Lee SB, Taylor JWT (1990) Amplification and direct sequencing of fungal ribosomal RNA genes for phylogenetics. In: Innis MA, Gelfand DH, Sninsky JJ, White TJ (Eds.). PCR protocols: a guide to methods and applications. Academic Press, New York 315–322. https://doi.org/10.1016/B978-0-12-372180-8.50042-1
Wie J, Gao W, Huang C-Y (2021) A checklist of edible ectomycorrhizal mushrooms in China. Mycosystema 40(8):1938–1957. https://doi.org/10.13346/j.mycosystema.210031.
Zambonelli A, Salomoni S, Pisi A (1993) Caratterizzazione anatomo-morphologica delle micorrize di Tuber spp. su Quercus pubescens Willd. Micol Ital (3):73–90
Zambonelli A, Salomoni S, Pisi A (1995) Caratterizzazione anatomo-morfologica delle micorrize di Tuber borchii, Tuber aestivum, Tuber mesentericum, Tuber brumale, Tuber melanosporum su Pinus pinea. Micol Ital 2:119–137
Zambonelli A, Iotti M, Hall IR (2015) Current status of truffle cultivation: recent results and future perspectives. Micol Ital 44:31–40. https://doi.org/10.6092/issn.2465-311X/5593
Zambonelli A, Iotti M, Giomaro G, Hall IR, Stocchi V (2002) T. borchii cultivation: an interesting perspective. Edible mycorrhizal mushrooms and their cultivation. In: Hall I, Wang Y, Danell E, Zambonelli A (eds) Edible mycorrhizal mushrooms. Proceedings of 2nd international workshop on edible ectomycorrhizal mushrooms, New Zealand Institute for Crop and Food Research Limited Current status of truffle cultivation: recent results and future perspectives, CD room. 3–6 July 2001, Christchurch, New Zealand
Zambonelli A, Iotti M, Puliga F, Hall IR (2021) Enhancing white truffle (Tuber magnatum Picco and T. borchii Vittad.) cultivation through biotechnology innovation. In: Advances in plant breeding strategies: vegetable crops 505–532 Springer, Cham. https://doi.org/10.1007/978-3-030-66969-0_14
Funding
The work was supported through projects “Etablierung einer Trüffelplantage in der Bergbaufolgelandschaft der Niederlausitz (Brandenburg)” and “Management und Vermarktung einer Trüffelplantage in der Niederlausitz (Brandenburg)”. The Slovenian part of study was funded by the Slovenian Research Agency through research project J4-1766 “Methodology approaches in genome- based diversity and ecological plasticity study of truffles from their natural distribution areas”, J4-3098 “The unrevealed information on soil biodiversity in leached waters”, J4-4547 “Climate changes and ectomycorrhizal fungi—how far can we go with an assisted migration of truffles?”, and the Research Program in Forest Biology, Ecology and Technology (P4-0107) of the Slovenian Research Agency.
Author information
Authors and Affiliations
Contributions
All authors contributed to the study conception and design. All authors participated at various stages of material preparation, data collection, and analysis. The first draft of the manuscript was written by Tanja Mrak, and all authors commented on previous versions of the manuscript. All authors read and approved the final manuscript.
Corresponding author
Ethics declarations
Competing interests
The authors declare no competing interests.
Additional information
Publisher's Note
Springer Nature remains neutral with regard to jurisdictional claims in published maps and institutional affiliations.
Supplementary Information
Below is the link to the electronic supplementary material.
Rights and permissions
Open Access This article is licensed under a Creative Commons Attribution 4.0 International License, which permits use, sharing, adaptation, distribution and reproduction in any medium or format, as long as you give appropriate credit to the original author(s) and the source, provide a link to the Creative Commons licence, and indicate if changes were made. The images or other third party material in this article are included in the article's Creative Commons licence, unless indicated otherwise in a credit line to the material. If material is not included in the article's Creative Commons licence and your intended use is not permitted by statutory regulation or exceeds the permitted use, you will need to obtain permission directly from the copyright holder. To view a copy of this licence, visit http://creativecommons.org/licenses/by/4.0/.
About this article
Cite this article
Mrak, T., Grebenc, T., Friedrich, S. et al. Description, identification, and growth of Tuber borchii Vittad. mycorrhized Pinus sylvestris L. seedlings on different lime contents. Mycorrhiza 34, 85–94 (2024). https://doi.org/10.1007/s00572-023-01135-3
Received:
Accepted:
Published:
Issue Date:
DOI: https://doi.org/10.1007/s00572-023-01135-3